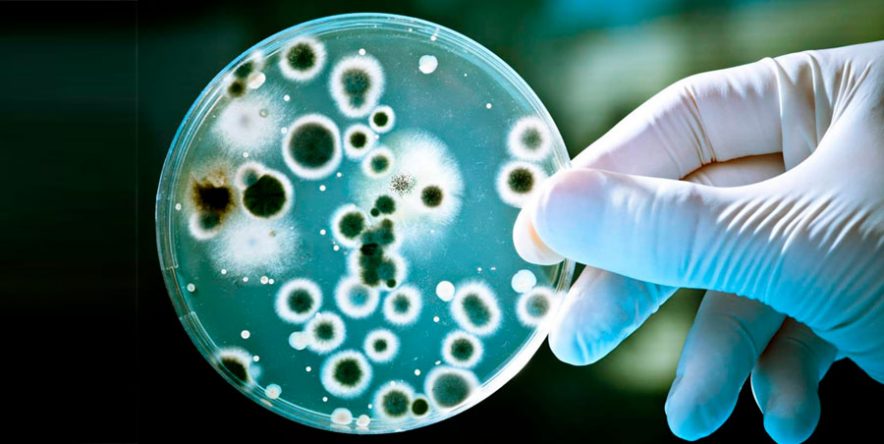

SAÚDE
ALERTA: ‘Superfungo’ resistente a medicação se espalha rapidamente pelo mundo
Identificado pela primeira vez no ouvido de uma mulher japonesa em 2009, o Candida Auris é um fungo emergente de difícil diagnóstico que vem se espalhando pelo mundo. Ele é resistente a praticamente todos os medicamentos existentes e passou a ser classificado como um “superfungo”. Sem uma análise especializada, ele pode ser confundido com vários outros tipos comuns.
Naturalmente, todo ser humano possuí a presença de fungos no corpo. Entretanto, o superfungo surge a partir do uso indiscriminado de antibióticos: sob a ação dos remédios, as bactérias vão morrendo e fazem com que os fungos acabem prosperando, surgindo as doenças fúngicas resistentes a antimicrobianos.
Em entrevista ao G1, o infectologista do Instituto de Infectologia Emílio Ribas, Jean Gorinchteyn, explica que o fácil contágio é uma de suas características mais preocupantes, podendo ser transmitida por diversos materiais hospitalares como estetoscópios, medidor de pressão, macas e termômetros.
“Além do fungo grudar em materiais hospitalares com facilidade, que favorece o contágio, existe uma dificuldade de sua retirada dos equipamentos. A limpeza acaba se tornando difícil, fruto de sua extrema aderência.”
Antes mesmo da Organização Pan-Americana de Saúde (OPAS) e a Organização Mundial de Saúde (OMS) divulgarem um alerta geral em 2016 sobre um novo fungo em países como Paquistão, Líbano, Israel, Espanha e Inglaterra, a Venezuela registrou os primeiros surtos na América Latina entre 2012 e 2013.
Desde então, vários países já confirmaram a presença do fungo em ambientes hospitalares, como Quênia, África do Sul, Kuwait e mais recentemente os Estados Unidos, que registrou 587 casos. Segundo o mapa do Centers For Disease Control and Prevention (CDC), atualizado fevereiro de 2019, já foram registrados casos em mais de 20 países. Não há casos registrados no Brasil.
Ainda segundo Gorinchteyn, apesar de ser uma questão de tempo até o Brasil vivenciar a presença do fungo, a Comissão de Infecção Hospitalar (CCIH) realiza um importante trabalho de prevenção.
“Pela proximidade com países como a Venezuela, onde existe a circulação do fungo, é uma questão de tempo para que nós o encontremos no nosso meio. (…) Felizmente nós temos a Comissão de Infecção Hospitalar (CCIH) que ajuda identificar a presença de bactérias e até mesmo os fungos, fazendo o controle frequente, seja nos pacientes que são admitidos nos hospitais para a internação ou em pacientes de UTI”, disse o infectologista.
Fonte G1





















